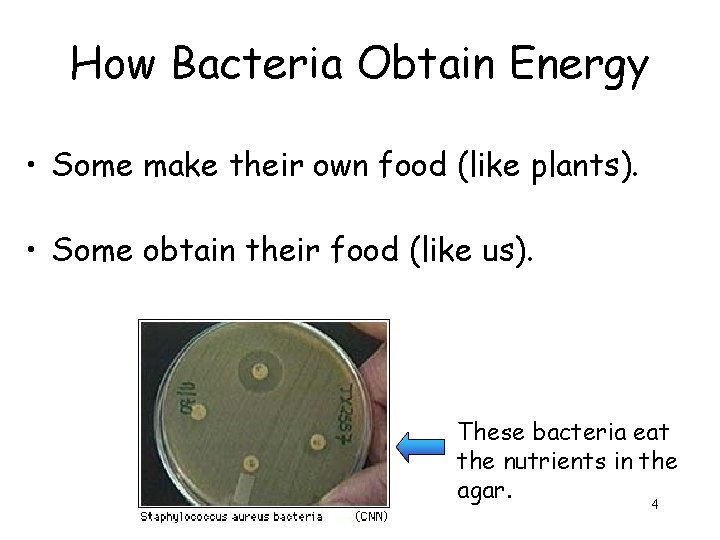
How Bacteria Obtain Energy • Some make their own food (like plants). • Some

VIRUSES Prokaryotes Chapter 20 1 2 The Structure

- Slides: 46
VIRUSES & Prokaryotes Chapter 20 1
2
The Structure of Bacteria • 3 basic shapes: rod, spherical & spiralshaped • No nucleus • Cell wall • Flagella or cilia for movement 3
How Bacteria Obtain Energy • Some make their own food (like plants). • Some obtain their food (like us). These bacteria eat the nutrients in the agar. 4
Reproduction in Bacteria • Most reproduce through binary fission (asexual reproduction), making clones. 5
• Other bacteria exchange genetic information through conjugation (a. k. a. bacteria sex). • A hollow bridge forms between the 2 bacteria & genes move from 1 bacterium to the other. • The advantage- it increases genetic diversity. 6
• Bacteria that causes illness and disease. Ex: diphtheria, tuberculosis, typhoid fever, tetanus, syphilis, cholera, bubonic plague • How are the diseases caused? – Bacteria damage the cells & tissues of an organism by breaking them down for food. or – Bacteria release toxins (poisons) that travel through the organism’s body. 7
• Bacteria that humans use and need in their everyday lives. Escherichia coli (Esh-er-ish-e-ah coal-eye): one of many that live in your gut. Helps digest your food. 8
Lactobacillus acidophilus (lack-toe-bah -sill-us acid-off-ill-us): Turns milk into yogurt. Saccharomyces cerevisiae (sack-arrow-my-seas sairuh-vis-ee-ay): a. k. a. baker's yeast. Makes bread rise. Pseudomonas putida (suedoe-moan-us poo-teadah): Cleans wastes from sewage water at water treatment plants. 9
Streptomyces (streptoe-my-seas): soil bacteria that makes streptomycin, an antibiotic. Arbuscular mycorrhizas (ar-bus-que-ler my-kuhrye-zuh): one of a soilliving fungus family. Helps crops take up nutrients from the soil. Bacillus thuringiensis (bah-sill-us ther-in-gee-in-sis): a. k. a "Bt", a common soil bacterium. A natural pest-killer in gardens and on 10 crops.
Bacteria are Useful for: • • Nitrogen Fixation Recycling of Nutrients (decomposers) • • Foods & Medicines Producers Ex: Prochlorococcus accounts for more ½ of photosynthesis in open oceans. Antibiotics 11
How Do You Treat a Bacterial Infection? • If prevention fails, take antibiotics. • Antibiotics kill bacteria without harming the cells of humans or animals. – They interfere with the cellular processes of bacteria. • Many antibiotics are produced naturally by living organisms. Ex: penicillin • Others are synthetic (man-made). 12
13
Virus Facts • NONLIVING: can’t grow, develop, or respire and cannot replicate on their own. • ½ to 1/100 the size of the smallest bacterium. 14
What do viruses look like? • Made of a core of genetic material surrounded by a protein coat (capsid). • Come in a variety shapes: rod or tadpoleshaped; helical; cube like 15
How do viruses reproduce? • Viruses insert their genetic material into a host cell. – The capsid (outside protein) “tricks” the cell into allowing it inside. • Once inside, the viral genes take over. • The “hijacked” cell transcribes the viral genes, using the host cells own enzymes. • Lytic or Lysogenic Cycles 16
Viral Replication Cycles Lytic cycle: Virus infects the cell, copies itself & causes the host cell to burst (lyse). • ex: influenza (flu), cold, rabies, AIDS Lysogenic cycle: Virus infects the cell & inserts its genetic material into the hosts DNA. The host cell is not harmed. • ex: Herpes, Varicella (chicken pox), HIV http: //www. youtube. com/watch? v=Rpj 0 em. EGSh. Q
• Because viruses bind precisely to proteins on the host cell’s surface & use it’s genetic system, most viruses infect very specific types of cells. Ex: plant viruses infect plant cells, bacterial viruses infect bacteria (bacteriophages) 18
RETROVIRUSES • Contain RNA as their genetic material. Ex: HIV • Retroviruses infect a cell and produce a DNA copy of their RNA. (retro = backward; RNA is copied in to DNA) • This DNA is inserted into the host cell's DNA. 19
How Can You Protect Yourself From Viral Infections? • The best way: vaccines – Weakened or killed virus or viral proteins. – When injected, the vaccine stimulates the immune system. – Sometimes produces permanent immunity. • Protect yourself! – Stay away from known sick people. – Wash your hands often. 20
The Immune System and Disease Chapter 35
Infectious Disease 22
infectious disease: changes to body physiology that disrupt normal body functions caused by microorganisms pathogen: a disease-causing agent; causes infection -includes viruses, fungi, bacteria, protozoans & parasites
How are Diseases Spread? • • Coughing, sneezing, physical contact Exchange in body fluids Contaminated food & water Animal contact (zoonosis) – vector: animal carrier who transmits the disease, but doesn’t get sick themselves.
Defense Against Infection 25
Nonspecific Defenses • General defense against many different pathogens. • Include skin, tears & other secretions, inflammatory response, interferons & fever.
First Line of Defense ● Include skin, saliva, mucus, & tears. ● As long as they remain intact, they can keep out many pathogens.
Second Line of Defense 1. ) interferons: chemicals released by virusinfected cells that slow down the progress of infection & buy time for the immune system to respond 2. ) fever: higher body temperature slows down or stops the growth of some pathogens
3) inflammatory response • A tissue response to injury or infection, producing redness, swelling, heat & pain. • Chemicals released by damaged tissues attract white blood cells to the site. • The mass of white blood cells, bacterial cells & damaged tissue forms pus.
Specific Defenses = the Immune System • Very precise. • Recognize “self” & “other” (& kill the “other”). • Also known as immune response. • Slower to respond than non-specific defenses.
Antigens & Antibodies antigen: specific foreign molecules that trigger an immune response; usually located on a cell’s surface antibodies: tag antigens for destruction by the immune system – Shape allows it to bind to specific antigen. Body makes up to 10 billion different antibodies. – Antibodies may be free floating or attached to B cells.
Lymphocytes (White Blood Cells) Two Types: B cells • Produced & mature in red bone marrow. • Have embedded antibodies. • Discover antigens in body fluids. T cells • Produced in bone marrow & mature in thymus. • Must be presented with antigens by infected body cells or immune cells.
The Immune System • Two main types of specific immune response: 1. ) humoral immunity (pathogen is in fluids) 2. ) cell-mediated immunity (pathogen has invaded a cell) 33
Humoral Immunity 1. ) Antibodies on B cells bind to antigens in body fluids (like blood & lymph). 2. ) This stimulates rapid growth & division of B cells, both Plasma & Memory B cells. 3. ) Plasma B cells make more antibodies that tag the antigens for destruction. 4. ) Memory B cells remain alive after infection ends & quickly produce more Plasma B cells if the pathogen returns. (Why vaccinations work!) 34
Cell-mediated Immunity • T cells destroy body cells containing viruses, fungi & cancer. 1. ) Infected cell displays antigen on its outer surface. 2. ) T cells are activated & kill infected cells. 3. ) Memory T cells are also produced to respond quickly if the pathogen returns. • This is what causes organ rejection. 35
Fighting Infectious Disease & Health 36
Vaccination • Consists of pathogens that have been weakened or killed so they cannot cause a serious infection. • Includes antigens that stimulate an immune response, but do not produce the severe symptoms of disease.
Acquired Immunity Active Immunity: Person produces an immune response to the antigen (including memory B & T cells) from either direct exposure (fighting the infection) or vaccination. Passive Immunity: Antibodies produced against a pathogen by other individuals or animals produce temporary immunity. Ex: rabies antibody serum, mother to fetus, breast milk
Public Health Prevention of Diseases Spreading 1. ) Regulating food and water supplies. – Cholera, Typhoid, Guinea worm
Public Health Prevention of Diseases Spreading 2. ) Promoting vaccinations. • Herd Immunity
Herd Immunity
Public Health Prevention of Diseases Spreading 3. ) Promoting behaviors that avoid spread of infection.
New and Re-Emerging Diseases • Many diseases were eliminated or were under control in the 1980 s (e. g. polio & smallpox). • Over the past decade, we have had a resurgence of old diseases and introduction of new diseases (Ebola, SARS, hantavirus). • Why has this happened? ?
Reasons for New and Re. Emerging Diseases 1. ) Changing interactions with Animals: – Human & animal habitats combine. – Trade of exotic animals.
Reasons for New and Re. Emerging Diseases 2. ) Misuse of Antibiotics & medications: – Not following instructions on medication. – Overuse of antibiotics is causing resistance. P a n d e m i c s